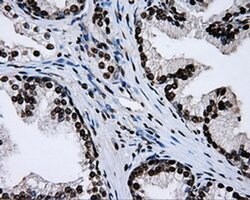
RPA2 Mouse anti-Human, Clone: OTI9A1, liquid, TrueMAB 100 &mu;L; Unconjugated:Antibodies,

missing translation for 'onlineSavingsMsg'
Learn More
Learn More
RPA2 Mouse anti-Human, Clone: OTI9A1, liquid, TrueMAB™
Mouse Monoclonal Antibody
Brand: Origene Technologies TA500763

This item is not returnable.
View return policy
Description
Required for DNA recombination, repair and replication. The activity of RP-A is mediated by single-stranded DNA binding and protein interactions. Required for the efficient recruitment of the DNA double-strand break repair factor RAD51 to chromatin in response to DNA damage.Specifications
| RPA2 | |
| Monoclonal | |
| 0.7 mg/mL | |
| PBS with 1% BSA, 50% glycerol and 0.02% sodium azide | |
| P15927 | |
| RPA2 | |
| Full length human recombit protein of human RPA2 produced in HEK293T cell. | |
| 100 μL | |
| Primary | |
| Human | |
| Antibody | |
| IgG1 |
| Flow Cytometry, Immunocytochemistry, Immunofluorescence, Immunohistochemistry (Paraffin), Immunoprecipitation | |
| OTI9A1 | |
| Unconjugated | |
| RPA2 | |
| REPA2, RP-A p32, RP-A p34, RPA32 | |
| Mouse | |
| Affinity Chromatography | |
| RUO | |
| 6118 | |
| -20° C, Avoid Freeze/Thaw Cycles | |
| Liquid |
Product Content Correction
The Fisher Scientific Encompass Program offers items which are not part of our distribution portfolio. These products typically do not have pictures or detailed descriptions. However, we are committed to improving your shopping experience. Please use the form below to provide feedback related to the content on this product.
Product Title
Spot an opportunity for improvement?Share a Content Correction